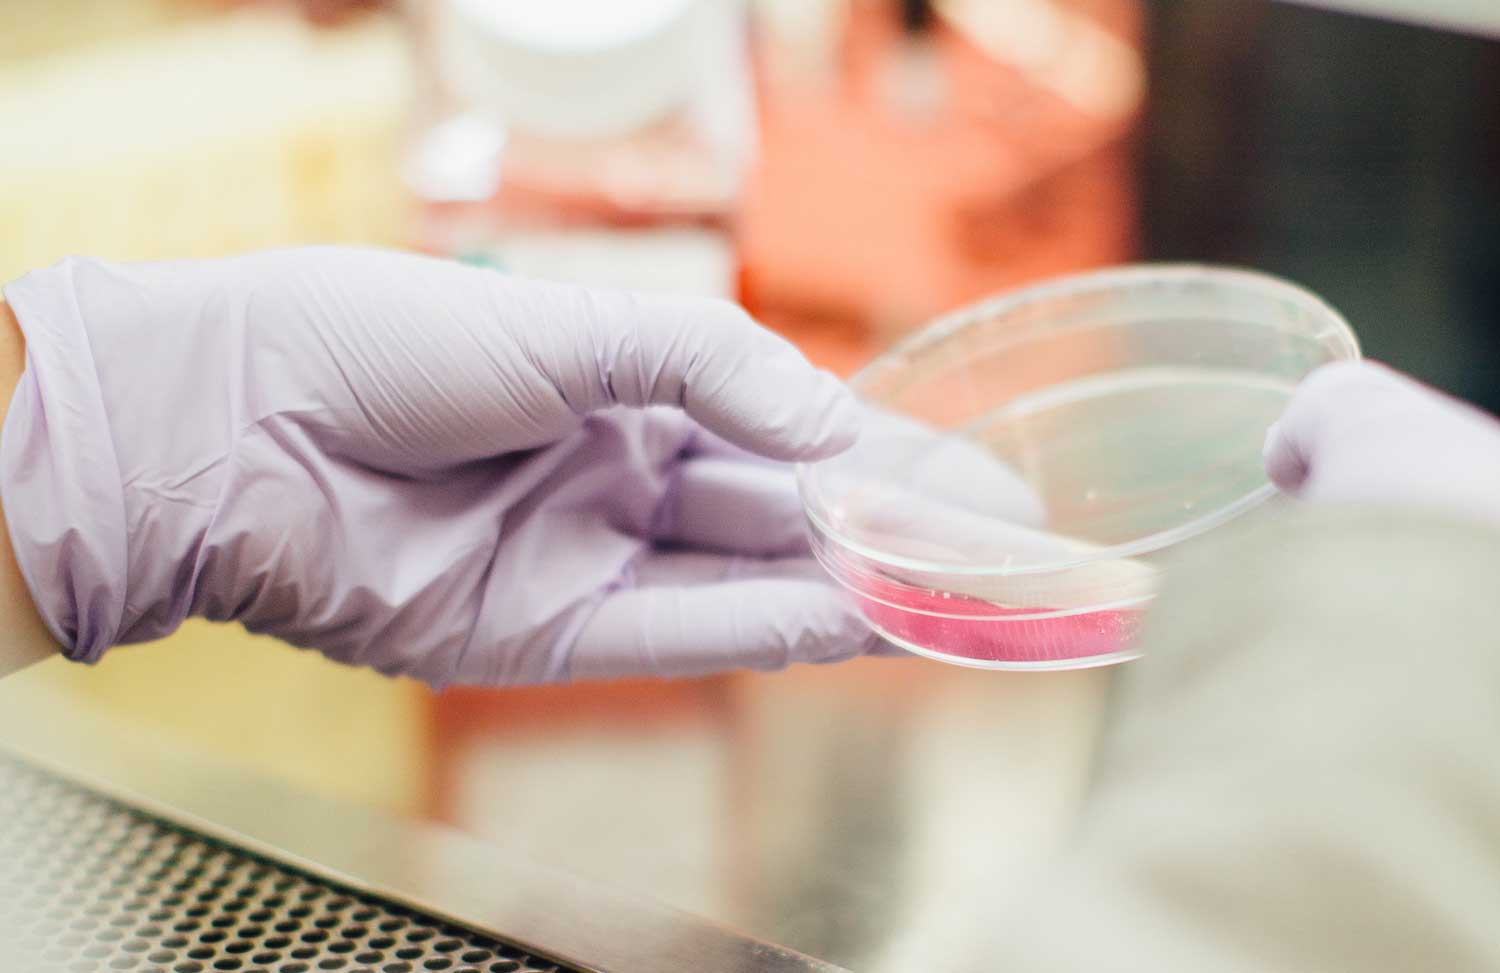

What is a genetic counsellor?
Genetic counsellors see patients with questions about their personal and familial risks for rare diseases, and to facilitate genetic testing after a thorough evaluation and discussion about the pros and cons of testing for each individual.
Through this process , genetic counsellors help people to make informed decisions about their health.
Areas of expertise
I see a wide range of individuals and families who are concerned about inherited conditions.
The reasons that a person might consult a genetic counsellor can include the following:
A personal or family history of a genetic condition, birth defect, chromosomal disorder, or hereditary cancer.
Two or more pregnancy losses (miscarriages), a stillbirth, or a baby who died.
A child with a known inherited disorder, a birth defect, intellectual disability, or developmental delay.
A woman who is pregnant or plans to become pregnant at or after age 35. (Some chromosomal disorders occur more frequently in children born to older women.)
Testimonials



What to expect during a consultation
Before we meet for the first time, it is useful to gather as much information as possible about the family history of the condition in the family, including diagnoses and ages of onset. This usually takes place over the phone or via an online meeting platform.
If you are in the Cape Town Southern Suburbs and South Peninsula areas, we can have an in-person consultation. Online sessions can also be arranged for local, national and international consultations.
To book your consultation, please email me at gillian@geneticsconsult.co.za or call 021 785 2726